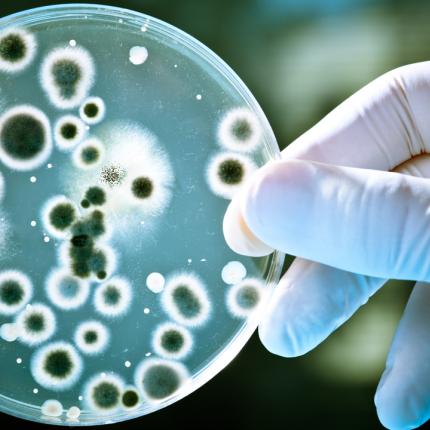
nanomedicine.jpg

Πλατφόρμα Νανοϊατρικής, που ως σκοπό έχει τη σύνδεση των ερευνητικών ιδρυμάτων και πανεπιστημίων που ασχολούνται με τη Ναν
Αύριο Τρίτη διεξάγεται η ηλεκτρονική ψηφοφορία για την ανάδειξη πρύτανη στο Αριστοτέλειο Πανεπιστήμιου
Νέο καμπανάκι για τη λειτουργία του ΑΠΘ κρούουν οι πρυτανικές Αρχές του ιδρύματος.
Υπό κατάληψη τελεί από τα ξημερώματα το κτίριο διοίκησης του Αριστοτελείου Πανεπιστημίου Θεσσαλονίκης (ΑΠΘ) από ομάδα περί
Ένταση σημειώθηκε νωρίς το πρωί έξω από το χώρο του Αριστοτελείου Πανεπιστημίου Θεσσαλονίκης, όταν ομάδα αγνώστων εκτόξευσ
Το θέμα της διαγραφής των λεγόμενων "αιώνιων" φοιτητών, συζήτησε στη συνεδρίαση της η Σύγκλητος του ΑΠΘ. Όπως...
Με νέες διοικήσεις ξεκινούν «εξεταστική περίοδο» έντεκα AEI της χώρας, ενώ προβληματισμός και ανησυχία επικρατούν...
Αντιμέτωπος με τις κατηγορίες της απάτης και της πλαστογραφίας, σε βαθμό κακουργήματος, είναι αναπληρωτής καθηγητή
Υπέρβαση σε ποσοστό 16,8% από τους στόχους για το πρώτο τρίμηνο του 2014 είχαν τα 27 νομικά πρόσωπα και φορείς της Γενικής...
Δεν κοιμούνται αρκετά οι φοιτητές του ΑΠΘ, η πλειονότητα των οποίων θεωρεί ότι χρειάζεται παραπάνω ώρες ύπνου.
Άλλη μία επιχείρηση πραγματοποίησε η ΕΛ.ΑΣ.